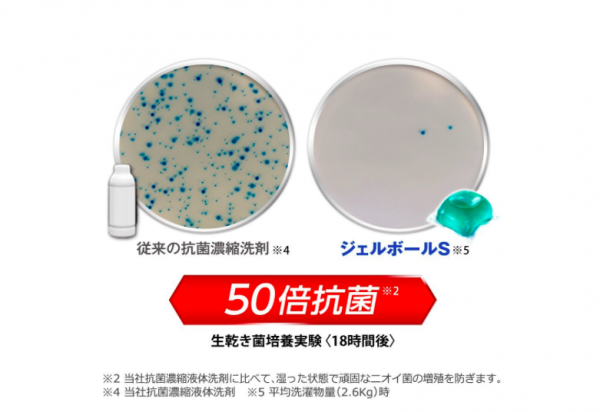
日本 P&G - 洗衣膠球-藍色抗菌-18顆入/袋*6

首載 App 現領 $ 100 折價券
 ( 10000+ )
( 10000+ )
1/1
商品特色
徹底洗淨衣物消臭,不沾手設計使用便利
高洗淨力及高濃度香氛,洗後衣物散發潔淨清香
抗菌, 除垢, 護理衣物,一次完成
有效預防因潮濕產生的異味
適用於一般及滾筒式洗衣機

口碑嚴選

正品保證

加密付款

7天鑑賞
付款
信用卡・LINE Pay・街口支付・先享後付・ATM・貨到付款
配送
宅配
免運
註冊新會員立即領首購免運券
486 則熱心媽咪評論
真實承諾
日本 P&G - 洗衣膠球-粉紅牡丹花香+柔軟精-18顆入/袋
用過1次就會愛上它.現在家人姊妹也一起用,真的是太棒了。洗完衣服超香的 。大推
日本 P&G - 洗衣膠球-粉紅牡丹花香+柔軟精-18顆入/袋
出貨速度快速,商品品質cp值優,外包裝很細心,還特地用氣泡袋裝起來,避免洗衣膠球破掉!
日本 P&G - 洗衣膠球-粉紅牡丹花香+柔軟精-18顆入/袋
(綠色抗菌除垢)
(粉紅牡丹香氣)
(淺藍桂花清香)
徹底洗淨衣物消臭,不沾手設計使用便利,洗後散發潔淨清香,有效預防因潮濕產生的異味,滾筒式洗衣機也適用唷~很棒的產品
日本 P&G - 洗衣膠球-粉紅牡丹花香+柔軟精-18顆入/袋
哇 99元真的便宜ㄝ 好用 好香 希望下次還有99元的價錢ㄡ
日本 P&G - 洗衣膠球-粉紅牡丹花香+柔軟精-18顆入/袋
超級好用的,用過就回不去了
日本 P&G - 洗衣膠球-粉紅牡丹花香+柔軟精-18顆入/袋
好用方便,隨手丟一顆,衣服乾淨又香又柔軟
日本 P&G - 洗衣膠球-綠色消臭-18顆入/袋
膠囊洗衣球使用超方便,不用再煩惱用量多少,味道很清香洗後的衣服味道很好👍
日本 P&G - 洗衣膠球-綠色消臭-18顆入/袋
出貨速度快速,商品品質cp值優,外包裝很細心,還特地用氣泡袋裝起來,避免洗衣膠球破掉!
日本 P&G - 洗衣膠球-綠色消臭-18顆入/袋
(綠色抗菌除垢)
(粉紅牡丹香氣)
(淺藍桂花清香)
徹底洗淨衣物消臭,不沾手設計使用便利,洗後散發潔淨清香,有效預防因潮濕產生的異味,滾筒式洗衣機也適用唷~很棒的產品
日本 P&G - 洗衣膠球-陽光香氛-18顆入/袋
好方便的膠球 又香 又便宜
期待下次的特價 99元
日本 P&G - 洗衣膠球-陽光香氛-18顆入/袋
只能搶購到ㄧ件,下次還有這實惠價格,會考慮回購,客服服務超好的
日本 P&G - 洗衣膠球-陽光香氛-18顆入/盒
出貨速度快速,商品品質cp值優,超讚賣家!
介紹

使用方法:
1.以乾燥的手取出洗衣球直接放入洗衣槽中(建議放在洗衣槽底部,及衣物底部)啟動洗衣模式即可
2. 水量30L-65L / 洗滌物2.0-6.0公斤洗滌效果最佳
保存方式:請放置於密閉容器中, 避免高溫及潮溼, 開封後請盡速使用完畢

看更多


